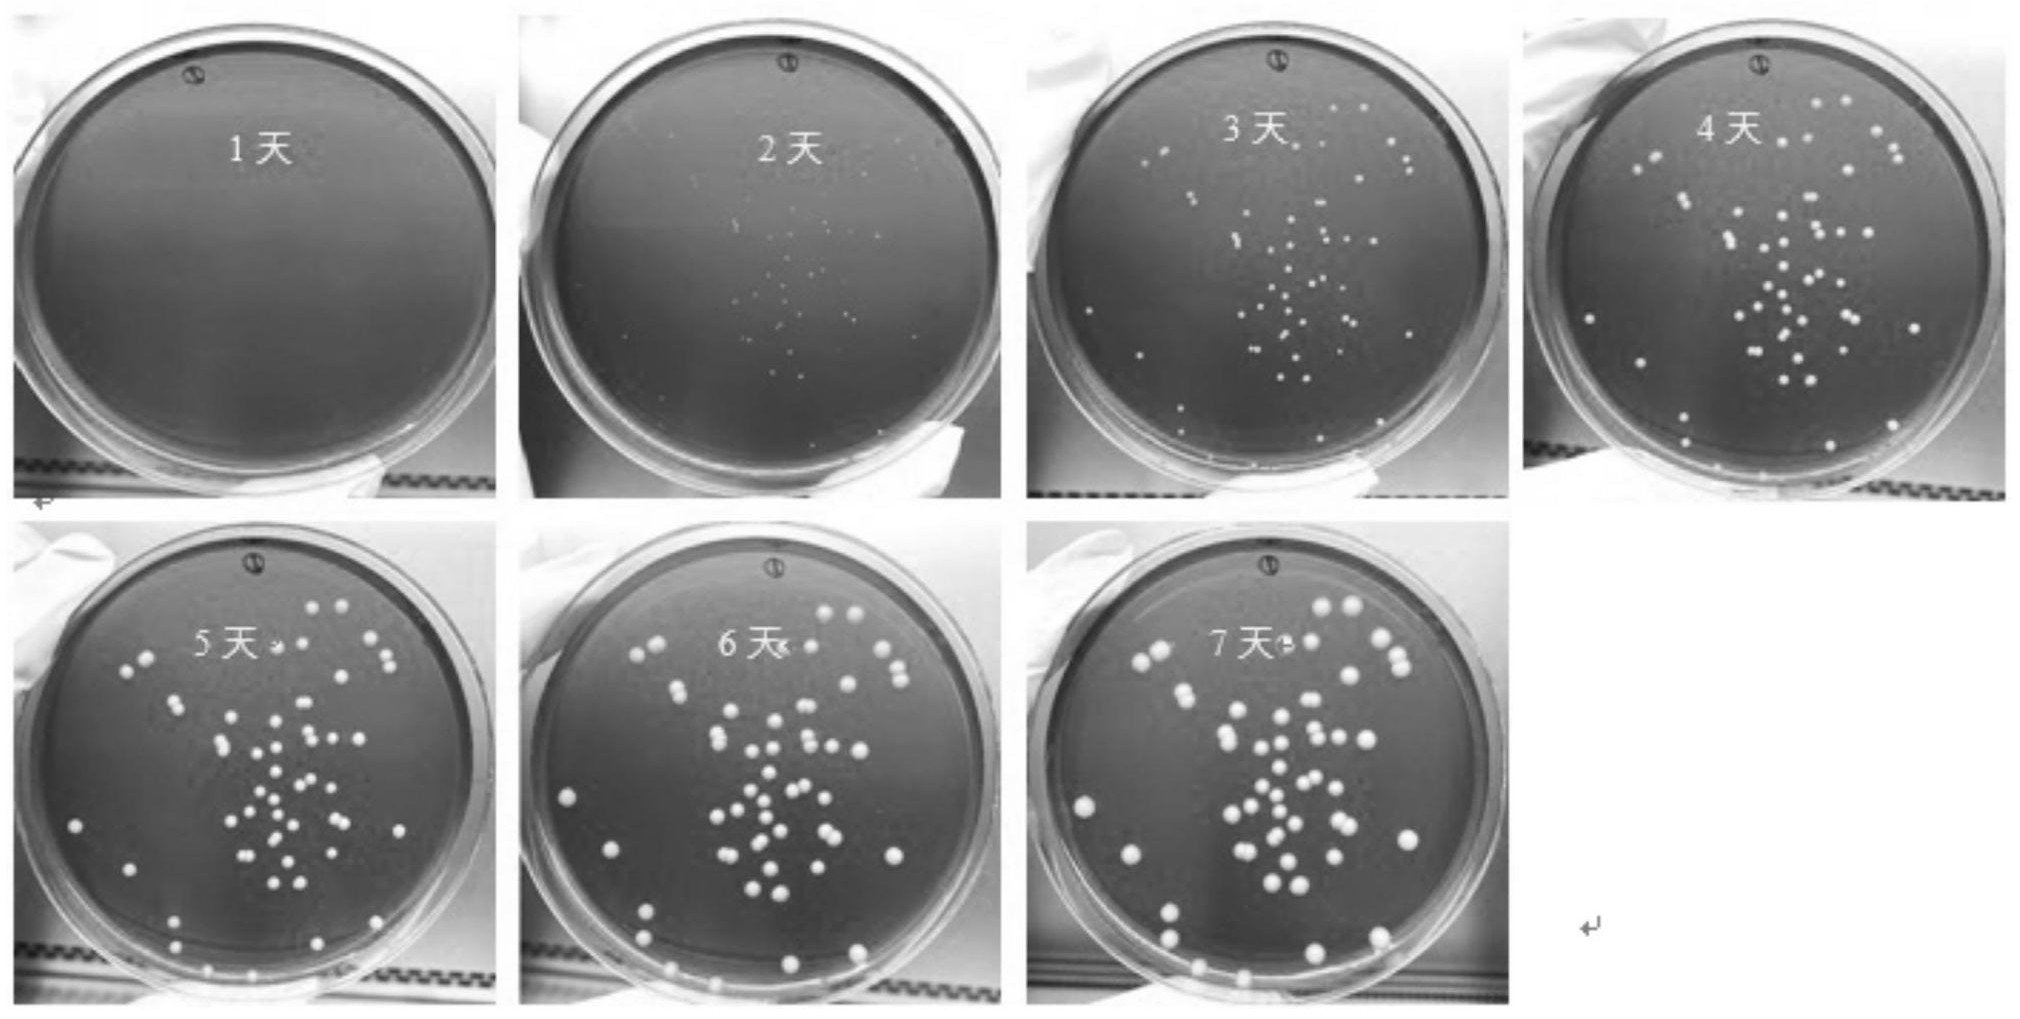

图片来源于网络,如有侵权,请联系删除
证券之星消息,根据天眼查APP数据显示四方光电(688665)新获得一项发明专利授权,专利名为“一种宽域型氧传感器芯片及其制备方法”,专利申请号为CN202510289553.1,授权日为2025年6月10日。
专利摘要:本发明公开了一种宽域型氧传感器芯片及制备方法,芯片基体层由第一介质层、第二介质层、第三介质层和第四介质层组成;第一介质层上设有泵氧外电极;第一介质层和第二介质层之间设有泵氧内电极;第二介质层和第三介质层之间设有参考电极,第三介质层和第四介质层之间设有加热器;其中参考电极的电极部与泵氧内电极在第三介质层的投影方向上至少部分重合且参考电极的电极部设有离子阻挡层。本发明通过设置参考电极的位置,并在参考电极上设置离子阻挡层来减小泵氧内电极的上、下电极到参考电极的离子扩散路径差异,使得芯片不仅能达到目标内阻,测试精度高,而且在动态气氛中λ=1.0附近测试数据准确,没有杂波信号影响。
今年以来四方光电新获得专利授权13个,较去年同期增加了18.18%。结合公司2024年年报财务数据,2024年公司在研发方面投入了1.13亿元,同比增37.6%。
数据来源:天眼查APP
以上内容为证券之星据公开信息整理,由AI算法生成(网信算备310104345710301240019号),不构成投资建议。





